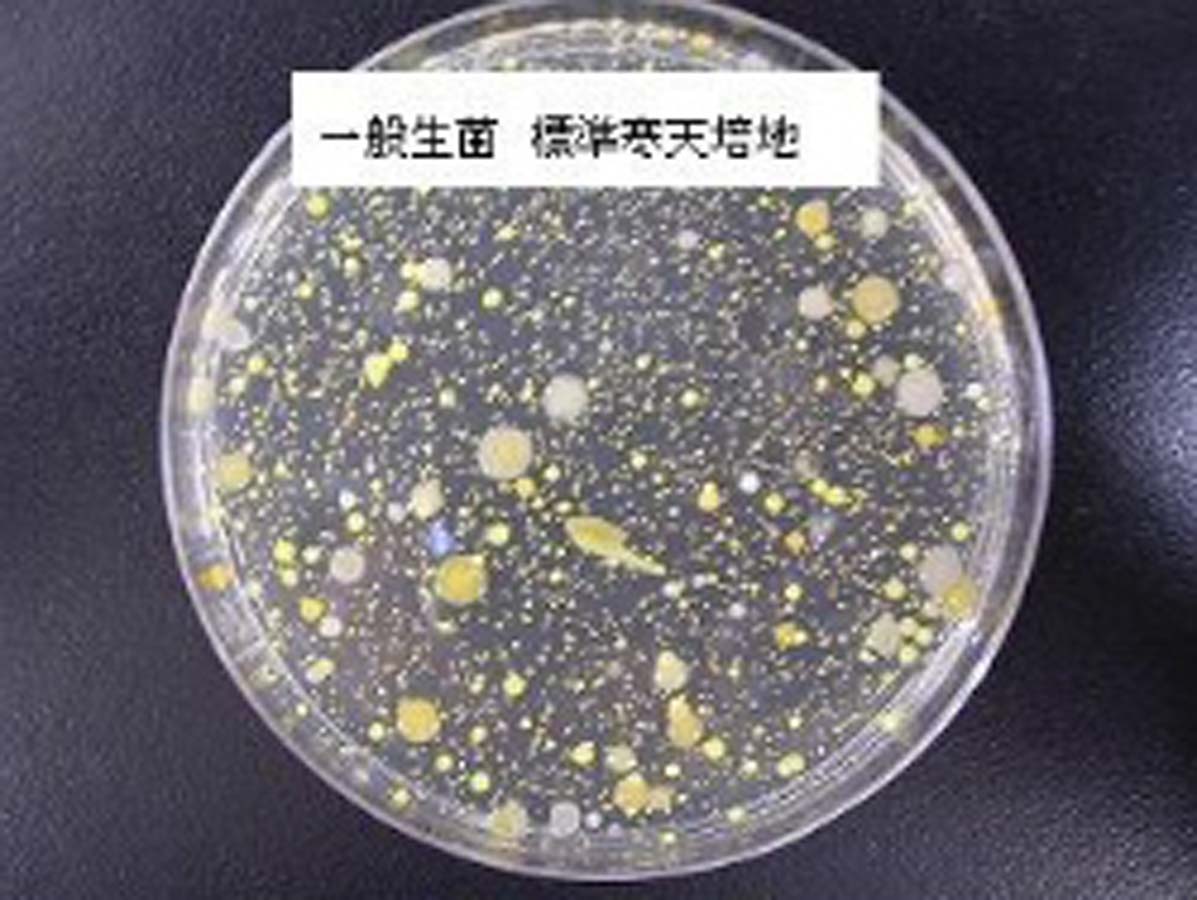

- 1 : 2025/04/20(日) 13:53:54.62 ID:ZsWMoq/k0
-
船橋の飲食店で食中毒、鶏レバーやねぎまなど食べた20代女性2人 カンピロバクター菌の一種が検出
4/19(土) 12:11配信
https://news.yahoo.co.jp/articles/d8bb8652d004beac846bd1a875f2a6bf641b3894 - 2 : 2025/04/20(日) 13:54:21.25 ID:ZsWMoq/k0
-
船橋市保健所は18日、同市前原西2の飲食店「鳥貴族津田沼店」で食事をした1グループ2人に下痢や発熱、腹痛の症状が出たと発表した。
2人の便からカンピロバクター菌の一種が検出されたことなどから、この食事が原因の食中毒と断定し、同津田沼店を同日から3日間の営業停止処分とした。2人は回復傾向にある。
市保健所によると、2人はいずれも20代の女性。
8日に同店で鶏レバーやねぎまなどを食べ、11日から症状が出たという。
- 3 : 2025/04/20(日) 13:55:00.03 ID:4+IN0Dst0
-
顔次第でその下痢高価で買い取るよ
- 4 : 2025/04/20(日) 13:55:28.28 ID:apul2beB0
-
鶏はヤバいっつてんだろ
鶏刺しとか正気の沙汰じゃねえぞ - 13 : 2025/04/20(日) 13:58:03.39 ID:hachkqFK0
-
>>4
鳥刺しはあくまでも「火を通さないのは客の意思」って建前でやってるからな - 5 : 2025/04/20(日) 13:55:49.17 ID:B+jj4x6z0
-
臭わせろ
- 6 : 2025/04/20(日) 13:56:04.39 ID:hsIIYth60
-
火の通りが甘かったのかな
鳥貴族も外人店員ばっかになったよな - 7 : 2025/04/20(日) 13:56:18.14 ID:ELLLn3YX0
-
だいぶウンチが近いよね
- 8 : 2025/04/20(日) 13:56:56.92 ID:Fjcx9Qex0
-
焼き鳥で食中毒とか相当杜撰な食材管理してるとか思えん
- 10 : 2025/04/20(日) 13:57:21.09 ID:3L5TVrNV0
-
ご尊顔拝ませろや
- 12 : 2025/04/20(日) 13:57:32.85 ID:5L9x/NqC0
-
鳥貴族で鶏刺し食えるのか
- 14 : 2025/04/20(日) 13:58:21.70 ID:lp43Wz3j0
-
鳥貴族で飲むような女なんて
- 15 : 2025/04/20(日) 13:58:39.91 ID:DzUw7M5+0
-
後遺症とかないよね?😟
- 16 : 2025/04/20(日) 13:59:00.44 ID:pBvXJxt50
-
鶏の生焼けはだいたい当たる
- 17 : 2025/04/20(日) 14:00:03.30 ID:/h7sbiXHd
-
ヒリついてる肛門に軟膏塗ってあげたい🥺
- 19 : 2025/04/20(日) 14:00:40.79 ID:lAOAhtJ10
-
これがゲリノミクスか
- 20 : 2025/04/20(日) 14:00:44.20 ID:t9TbBmRq0
-
鳥貴族もあかんのか
- 21 : 2025/04/20(日) 14:02:09.27 ID:WACXhKQYr
-
鶏生レバーか?
- 22 : 2025/04/20(日) 14:02:41.19 ID:8oqbsEieM
-
鳥刺し過去に二回食って二回とも高熱嘔吐下痢蕁麻疹になったから絶対食わない
下痢止まらないゲロ止まらない高熱で動けないで生き地獄だった - 23 : 2025/04/20(日) 14:04:29.05 ID:cTQNoATt0
-
生焼けかねえ
怖いんだよカンピロバクターは後遺症残る時あるし - 24 : 2025/04/20(日) 14:05:20.67 ID:nPgJCMwb0
-
鳥は硬くなるまで焼くか柔らかく焼いて当たるかの2択しかないゴミ肉
- 25 : 2025/04/20(日) 14:05:20.76 ID:bYdFrhVYM
-
メガドライブみたいな下痢便してんじゃねーよ!!
- 26 : 2025/04/20(日) 14:06:09.42 ID:JMJhfcY70
-
ゆかとカオリが殺られたか
しかし2人は四天王最弱ククク - 27 : 2025/04/20(日) 14:06:33.68 ID:UqdBJPRX0
-
貴族でも生焼きになんの!?
- 28 : 2025/04/20(日) 14:08:42.53 ID:0C+XYLuq0
-
ご尊顔は?
- 29 : 2025/04/20(日) 14:11:34.06 ID:0Tu+mFLX0
-
外食の何が嫌ってそのものはちゃんと火が通ってても皿やら箸やらにドリップ飛んでたらこれなること
- 30 : 2025/04/20(日) 14:21:17.66 ID:48f8zggc0
-
外食はトリが一番怖い気がするわ
衛生管理に火入れ加減安バイトなんか信用できん



コメント